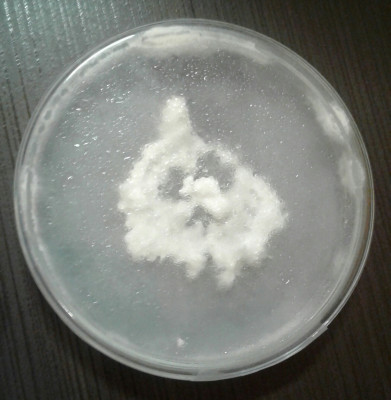
20200511_000539-1.jpg (1.11 MiB) 15401 mal betrachtet Petri15

Seite 7 von 15
Re: Hatte jemand schon Mal Erfolg mit einer Glucke ?
Verfasst: Dienstag, 28. April 2020 16:35
von malda
Zwischenstand nach einem Monat Glucken-Agar auf Weichholzansätzen. Nachdem die Glucke in den ersten Wochen nahezu keine Bestrebungen zeigte den Agar zu verlassen und ins Holz einzuwachsen tut sich nun langsam etwas. Getestet habe ich Weichholz mit Hefe und verschiedene Kohlenstoffquellen als Zusatz (alles steril/autoklaviert). Unten ist der beste Ansatz zu sehen => Zusatz von Hefe + vergorenen Mirabellen. Ähnlich „gut“ war ein Ansatz mit vergorenem Apfeltrester, aber der ist inzwischen weggeschimmelt. Die Ansätze mit vergorenem Material waren/sind etwas besser als z.B. ein Glucose-Zusatz. Möglicherweise ist das ein pH Effekt?
Re: Hatte jemand schon Mal Erfolg mit einer Glucke ?
Verfasst: Freitag, 01. Mai 2020 10:49
von ohkw
Sieht doch schon mal gar nicht so über aus. Die Glucke scheint wirklich gerne einen relativ niedrigen PH Wert zu haben. Produziert selbst auch offenbar recht viel Essigsäure.
Auf den Molasse Platten wächst sie leider auch nicht wesentlich besser. Ich hätte die wohl ansäuern müssen.
Re: Hatte jemand schon Mal Erfolg mit einer Glucke ?
Verfasst: Sonntag, 03. Mai 2020 21:49
von malda
Ja, sie wächst... aber fürchterlich langsam. Bei dem Tempo wird sie früher oder später von einer Kontaminante überholt.... Ich bin überzeugt, dass Kiefernholz hier deutlich besser wäre. Leider ist es schwieriger als gedacht an solche Holzspäne in kleinen Mengen zu kommen. Und Sorten-rein schon gar nicht...

Re: Hatte jemand schon Mal Erfolg mit einer Glucke ?
Verfasst: Montag, 04. Mai 2020 06:53
von GrafDracula
malda hat geschrieben: Sonntag, 03. Mai 2020 21:49 Leider ist es schwieriger als gedacht an solche Holzspäne in kleinen Mengen zu kommen. Und Sorten-rein schon gar nicht...

Wenn du ehh nur kleine Mengen benötigst, dann würd ich in den Wald gehen, mir Kiefern suchen und dort nach abgebrochenen Ästen suchen. Die kannst du dann immer noch mit Säge, Axt und Hammern kleinmachen ...
Im Land Brandenburg wurden ja zu DDR-Zeiten damals fast ausschließlich Kiefern gepflanzt, weswegen es dort nur Kiefern gibt, vlt. gibts da ja nen Sägewerk wo man sowas herbekommen kann. Hier bei mir in Bayern hingegen gibt es fast ausschließlich Fichten, aber selbst hier stehen ab und zu einzelne Kiefern rum, wo ich mir Kienspan zum Feuermachen gesammelt habe.
Re: Hatte jemand schon Mal Erfolg mit einer Glucke ?
Verfasst: Montag, 04. Mai 2020 20:13
von malda
Ja, 1-2 Kilo Späne könnte man auch aus Ästen herstellen..., wenn man die Äste denn aufarbeiten kann. Aber ich bin da schon etwas faul, da gefällt mir der Brandenburg-Tip schon viel besser – sehr gute Idee!
Aber wie's manchmal so kommt habe ich hoffetlich heute eine brauchbare Substrat-Quelle aufgetan => ein Sägewerk, das überwiegend Kiefer, Lärche und Douglasie (also sog. Rotholz) verarbeitet

Re: Hatte jemand schon Mal Erfolg mit einer Glucke ?
Verfasst: Samstag, 09. Mai 2020 09:47
von mariapilz
am 2.5 habe ich 4 Substratgläser beimpft. obiges Glas ist bis jetzt das schönste. Buchensägemehl Pferdefutter 65% Substratfeuchtigkeit (auf einen halben Liter Leitungswasser 1 Teelöffel 6%iger Walnussessig)
malda wiso machst du dein Glas nur halbvoll? Zum fruchten stelle ich mir das nicht so praktisch vor.
Re: Hatte jemand schon Mal Erfolg mit einer Glucke ?
Verfasst: Montag, 11. Mai 2020 08:08
von mariapilz
nach 9 Tagen Wachstum
links: (Glas 3) Buchensägemehl Gerstenschrot 65% Substratfeuchtigkeit (auf 0,5 l Leitungswasser 1 Teelöffel 6 %iger Walnussessig)
rechts: (Glas 4) Buchensägemehl Pferdefutter 65% Substratfeuchtigkeit (auf 0,5 l Leitungswasser 1 Teelöffel 6%iger Walnussessig)
Glas1: Fichtensägemehl ~ 2 Wochen fermentiert ~ 4 % Buchensägemehl ~ 1% Wurm/Käferscheiße 65% Substratfeuchtigkeit (Leitungswasser)-> null Wachstum
Glas2: Verbrauchter shii Block (teilweise zersetzt/kompostiert ~65% Substratfeuchtigkeit (auf 0,5 l Leitungswasser 1 Teelöffel 6%iger Rotweinessig) -> ca. 1 cm Wachstum
alle Gläser mit Petri 2 beimpft
ich schließe daraus, dass das Pferdefutter schmeckt
gestern habe ich 4 weitere Substratmischungen beimpft
Re: Hatte jemand schon Mal Erfolg mit einer Glucke ?
Verfasst: Montag, 11. Mai 2020 19:00
von malda
mariapilz hat geschrieben: Samstag, 09. Mai 2020 09:47
malda wiso machst du dein Glas nur halbvoll? Zum fruchten stelle ich mir das nicht so praktisch vor.
Das sind nur ganz kleine Ansätze um zu schauen auf welchem Substrat die Glucke einigermaßen wächst... an fruchten denk ich noch gar nicht
Dein Pferdefutter-Ansatz sieht aber mal wirklich vielversprechend aus - da hast Du wohl einen Volltreffer gelandet! Das sieht richtig gut aus – so gut wächst bei mir der Kräuterseitlich nicht....
Was ist denn da im Pferdefutter drin? Hast Du mal an einen Pferdefutteransatz ohne Essigsäure gedacht? Würde mich ja mal brennend interessieren ob der pH hier eine große Rolle spielt...
Re: Hatte jemand schon Mal Erfolg mit einer Glucke ?
Verfasst: Dienstag, 12. Mai 2020 20:32
von mariapilz
malda hat geschrieben: Montag, 11. Mai 2020 19:00
Was ist denn da im Pferdefutter drin?
na alles was ein Pferdchen so braucht... Und das ist ganz schön viel... die Ingredienzen sind sehr schön aufgelistet. Eure Gedanken dazu interessieren mich
malda hat geschrieben: Montag, 11. Mai 2020 19:00
Hast Du mal an einen Pferdefutteransatz ohne Essigsäure gedacht?
habe ich gestern Abend gleich noch angemixt und sterilisiert. 2 Gläser. Heute Früh geimpft.
Glas10: Buchensägemehl Pferdefutter Leitungswasser. Geimpft mit 2 Stück von Petri 2.
Glas11: exakt gleiches Substrat wie Glas 10. Geimpft mit 2 Stück von Petri 15. 1 Stück aus einem dicht weiß bewachsenem Sektor der Petri. 1 Stück aus einem sehr dünn bewachsenem Sektor der Petri. Im Glas auf der gegenüberliegenden Seite platziert.... ich will da einfach mal schauen ob das einen Unterschied macht, denn Petri 2 (mit dieser Petri wurde das schön wachsendem Glas beimpft) war eine m. E. nicht sehr schöne (sehr dünn) Petri (hat sogar eine bakterielle Konti drauf) Ich wollte für die ersten Testgläser nicht gleich die vermeintlich schönen Petris verpulvern...

- Petri2
die Konti auf 9:00 Uhr sieht aus wie ausgeschnitten. Ich habe aber nichts herumgeschnitten
- Petri15
im Zentrum dick bewachsen, dann als ob nix wäre und am Rand wächsts aus dem Deckel raus
habe gestern einen Strich entlang der Myzel Grenze gezogen. Heute fotografiert

irgendwie kommt mir das suspekt vor. Es wächst wie "normales" Myzel. Ich habe damals beim Petri kochen aber keinen anderen Pilz bearbeitet.
Re: Hatte jemand schon Mal Erfolg mit einer Glucke ?
Verfasst: Mittwoch, 13. Mai 2020 20:57
von Stephan
malda hat geschrieben: Sonntag, 03. Mai 2020 21:49
Ja, sie wächst... aber fürchterlich langsam. Bei dem Tempo wird sie früher oder später von einer Kontaminante überholt.... Ich bin überzeugt, dass Kiefernholz hier deutlich besser wäre. Leider ist es schwieriger als gedacht an solche Holzspäne in kleinen Mengen zu kommen. Und Sorten-rein schon gar nicht...
Ihr habt doch ganz sicher alle eine Tischlerei in der Nähe und Kiefer ist ja nun relativ häufig verarbeitet. Da mal angefragt wenn mal nicht verleimtes Holz durch gehobelt wird soll er doch mal den Lehrling die spänesäcke wechseln lassen dann gibt's halt mal was in die kaffeekasse. Bei uns geht das alles in die Tonne. Leider haben wir sehr sehr selten vollholz von laubholz. Kiefer halt oft verleimt, aber hab ich auch schon Säcke weise nach Hause geschleppt für die kleinen nager als Einstreu
Re: Hatte jemand schon Mal Erfolg mit einer Glucke ?
Verfasst: Donnerstag, 14. Mai 2020 20:14
von Monti
Schön, dass ihr so tapfer an der Glucke dran bleibt!
Ich hatte ja mit der Breitblättrigen Glucke noch etwas experimentiert. Hatte Kiefernbrennholz gescheitet und durch den Gartenhäcksler gelassen. Anschließend gewässert und mit der Micro pasteurisiert. Das Wachstum der Breitbl.Glucke (sofern es die war) war nicht zu verachten. Leider ist dann alles grün geworden... Ein Glas mit Brut hab ich noch, werde damit aber nicht mehr experimentieren...
Re: Hatte jemand schon Mal Erfolg mit einer Glucke ?
Verfasst: Freitag, 15. Mai 2020 17:40
von malda
mariapilz hat geschrieben: Dienstag, 12. Mai 2020 20:32
na alles was ein Pferdchen so braucht... Und das ist ganz schön viel... die Ingredienzen sind sehr schön aufgelistet. Eure Gedanken dazu interessieren mich
Zu der Zusammensetzung von dem Pferdefutter würde ich sagen alles drin was das Pferd und der Pilz so braucht. Klingt aber auch sehr kontaminationsanfällig => viel Protein und einfach zu verwertende Kohlenhydrate. Bei den ganzen Zusatzstoffen in geringen Mengen kann ich nichts sagen wegen fehlender Ahnung.
mariapilz hat geschrieben: Dienstag, 12. Mai 2020 20:32
habe gestern einen Strich entlang der Myzel Grenze gezogen. Heute fotografiert

irgendwie kommt mir das suspekt vor. Es wächst wie "normales" Myzel. Ich habe damals beim Petri kochen aber keinen anderen Pilz bearbeitet.
Diese Wachstumsgeschwindigkeit....also mir ist das auch etwas suspekt.... wenn sich da mal keine Kontaminante eingeschmuggelt hat.... ansonsten ist's der Jackpot

Re: Hatte jemand schon Mal Erfolg mit einer Glucke ?
Verfasst: Freitag, 15. Mai 2020 17:43
von malda
Monti hat geschrieben: Donnerstag, 14. Mai 2020 20:14
Schön, dass ihr so tapfer an der Glucke dran bleibt!
was heißt hier tapfer... wir haben doch gerade erst angefangen

Re: Hatte jemand schon Mal Erfolg mit einer Glucke ?
Verfasst: Freitag, 15. Mai 2020 18:23
von mariapilz
malda hat geschrieben: Freitag, 15. Mai 2020 17:40
Zu der Zusammensetzung von dem Pferdefutter würde ich sagen alles drin was das Pferd und der Pilz so braucht. Klingt aber auch sehr kontaminationsanfällig => viel Protein und einfach zu verwertende Kohlenhydrate. Bei den ganzen Zusatzstoffen in geringen Mengen kann ich nichts sagen wegen fehlender Ahnung.
Danke für deine Bemühungen zur Analyse
ich leide auch unter fehlender Ahnung... Aber an Ideen mangelt es nicht.
apropos kontianfällig... Gestern habe ich aus Glas 3 (wächst auch ganz passabel vor sich hin) eine grüne Konti rausgelöffelt

der Patient ist ein Kämpfer.
malda hat geschrieben: Freitag, 15. Mai 2020 17:40
Diese Wachstumsgeschwindigkeit....also mir ist das auch etwas suspekt.... wenn sich da mal keine Kontaminante eingeschmuggelt hat.... ansonsten ist's der Jackpot
mittlerweile denke ich dass "die bekterielle Konti" auf Petri 2 gar keine ist, sondern ein anderer (Kultur-) Pilz... wie auch immer der da hingekommen ist. Noch etwas Geduld, dann sehen wir - hoffentlich - was wächst.
Re: Hatte jemand schon Mal Erfolg mit einer Glucke ?
Verfasst: Donnerstag, 21. Mai 2020 21:39
von mariapilz
mariapilz hat geschrieben: Dienstag, 12. Mai 2020 20:32
Glas11: exakt gleiches Substrat wie Glas 10. Geimpft mit 2 Stück von Petri 15. 1 Stück aus einem dicht weiß bewachsenem Sektor der Petri. 1 Stück aus einem sehr dünn bewachsenem Sektor der Petri. Im Glas auf der gegenüberliegenden Seite platziert.... ich will da einfach mal schauen ob das einen Unterschied macht, denn Petri 2 (mit dieser Petri wurde das schön wachsendem Glas beimpft) war eine m. E. nicht sehr schöne (sehr dünn)
das obere (sorry, bin kein Fotograf) Foto zeigt das Agarstück aus dem dicht weiß bewachsenem Sektor der Petri. Das untere Foto... Den dünn bewachsenen.
Meiner Meinung nach ist das "dicht weiße" Myzel schon "einen Schritt weiter Richtung Fruchkörperbildung" daher wächst es nicht mehr so gut/so schnell wie das andere. So. naja. Das war jetzt nur eine Beobachtung und muss nichts heissen... Ein Klon braucht auch mehr Zeit bis er anwachsen im Gegensatz zu einem Korn aus einer Brut... Aber fürs Wachstum auf der Petri wärs besser es wächst flach und bildet nicht solche "Klumpen" ... Jetzt wärs halt gut zu wissen wie man das steuern kann. Ist es das Agarmedium oder Licht (vom öfteren nachschauen ob es wächst...) Ich glaube eher es ist das Inokulant das schon "diese Information in sich trägt" oder wie ich das sagen soll.
Wie sind denn eure Petris (ohkw... Die mit dem "stacheligen Haufen" weitergewachsen??) Sind Sie denn weitergewachsen?